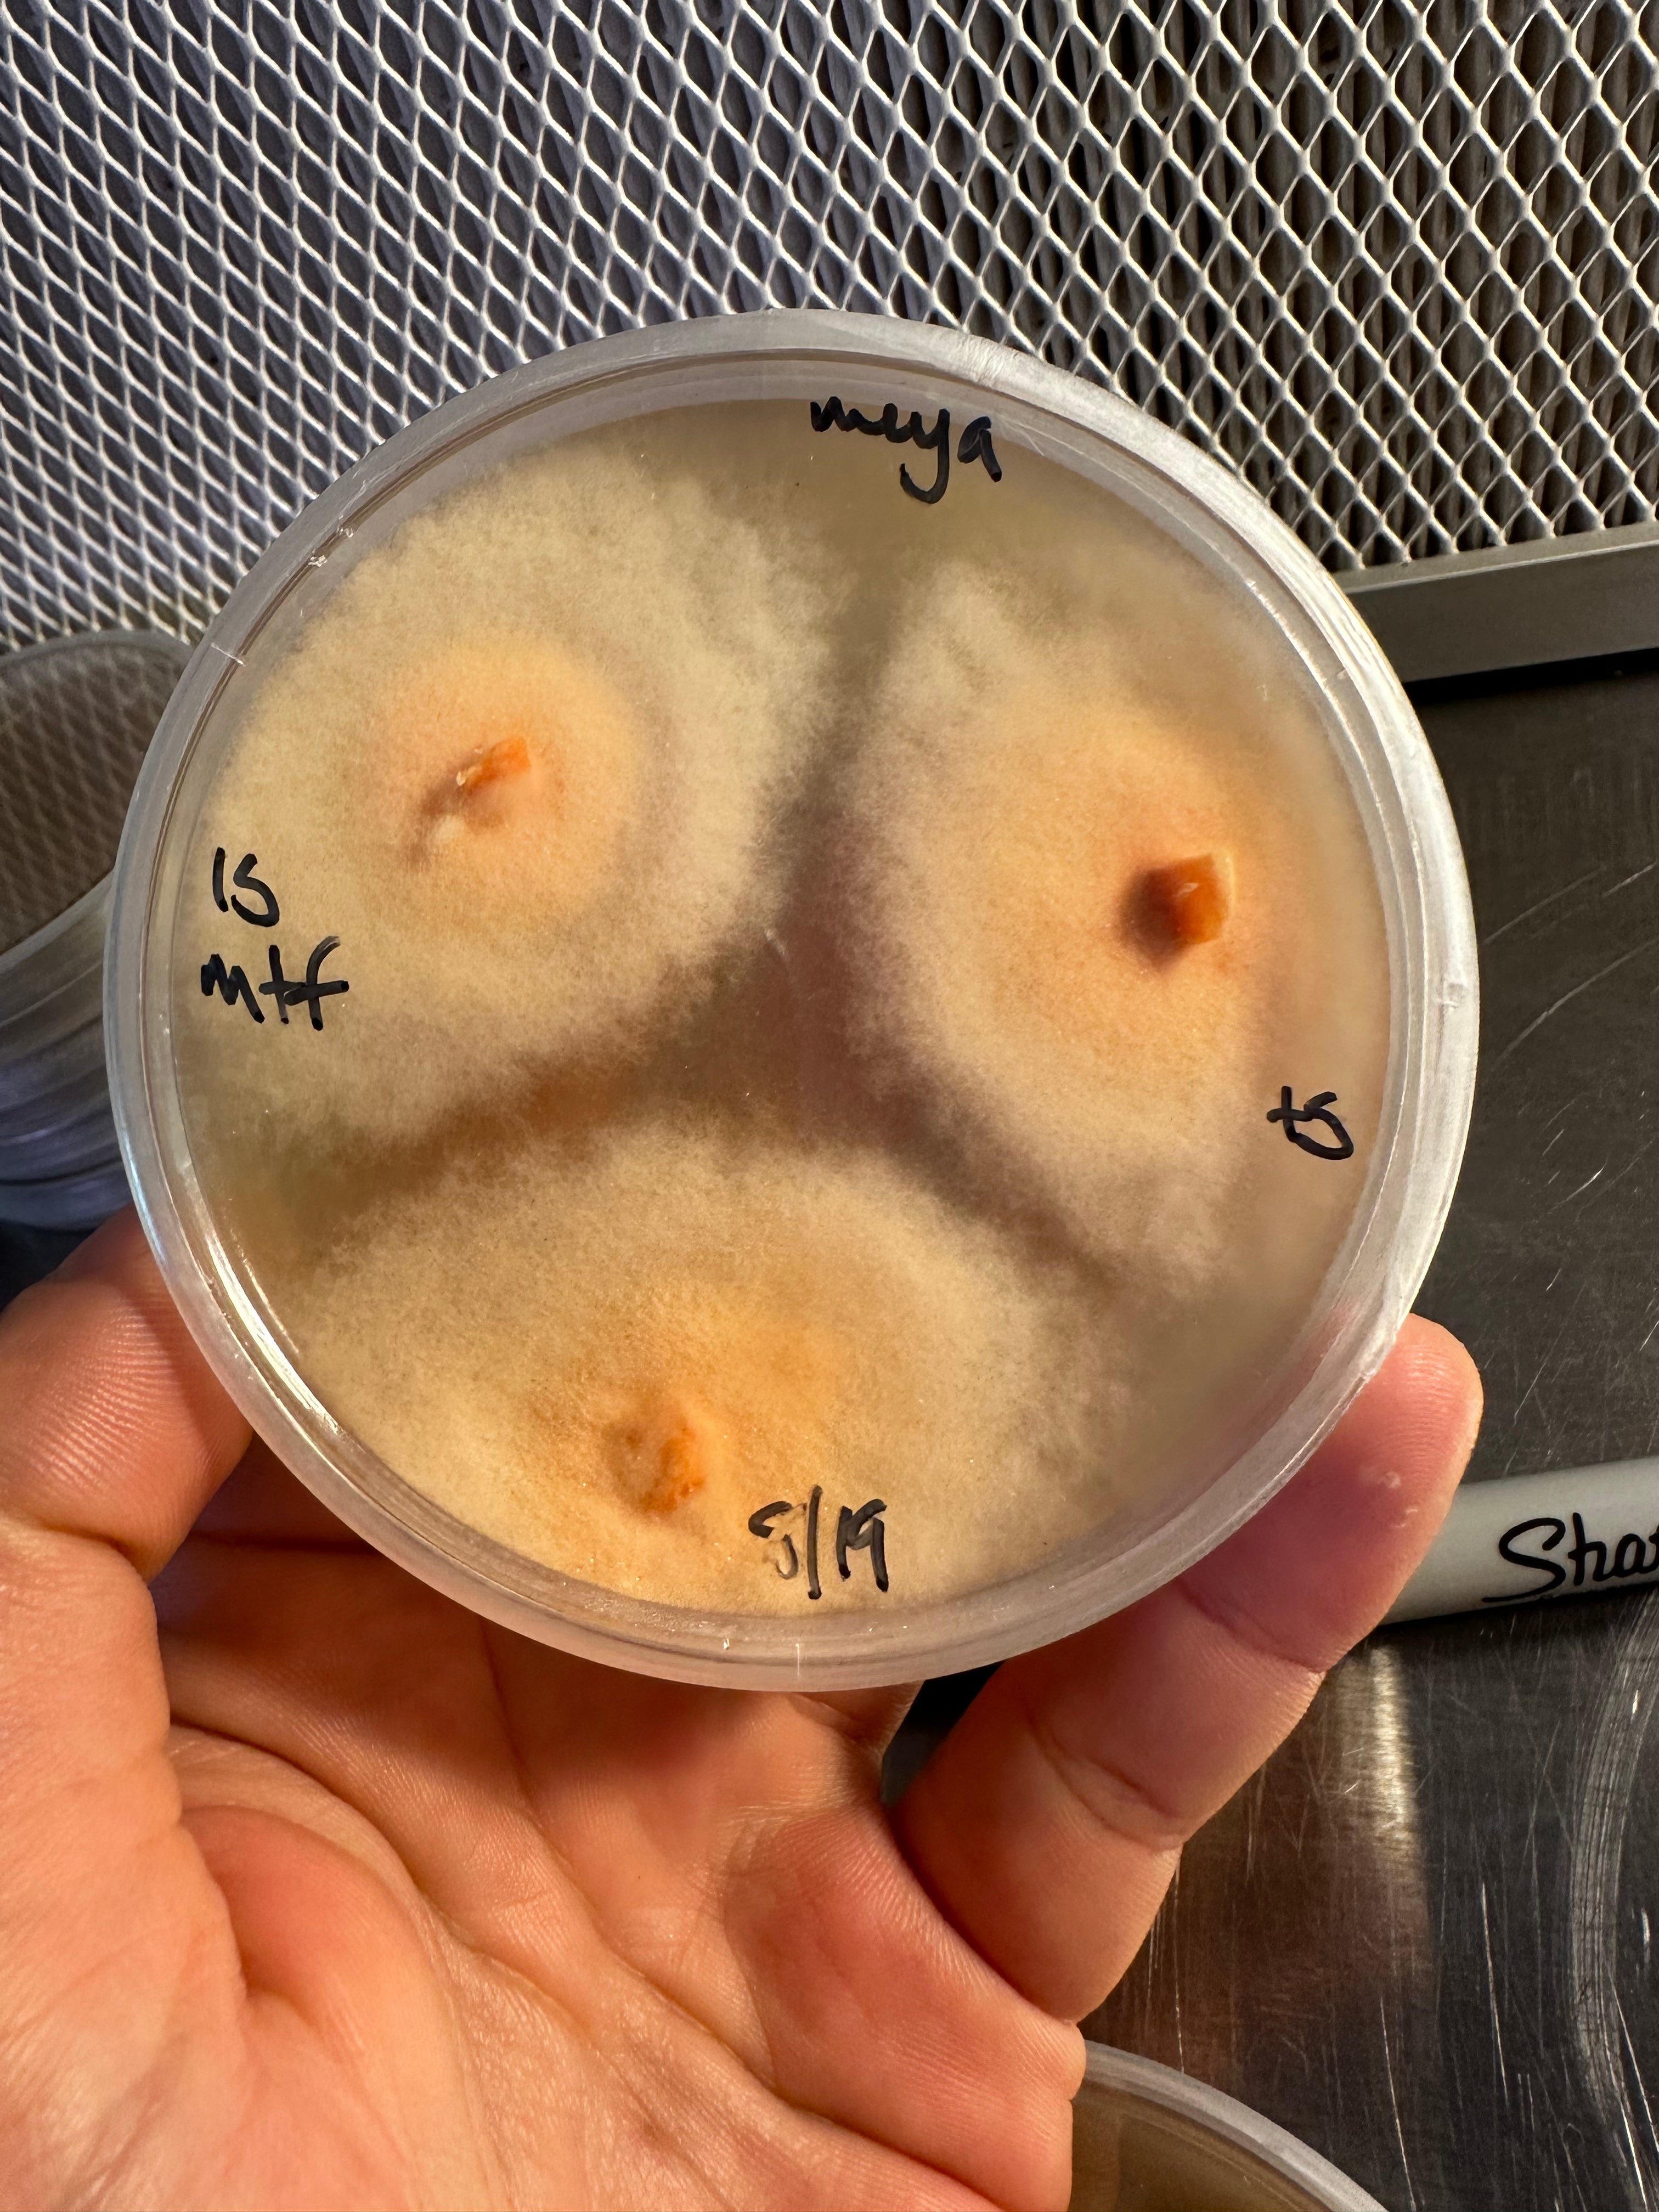
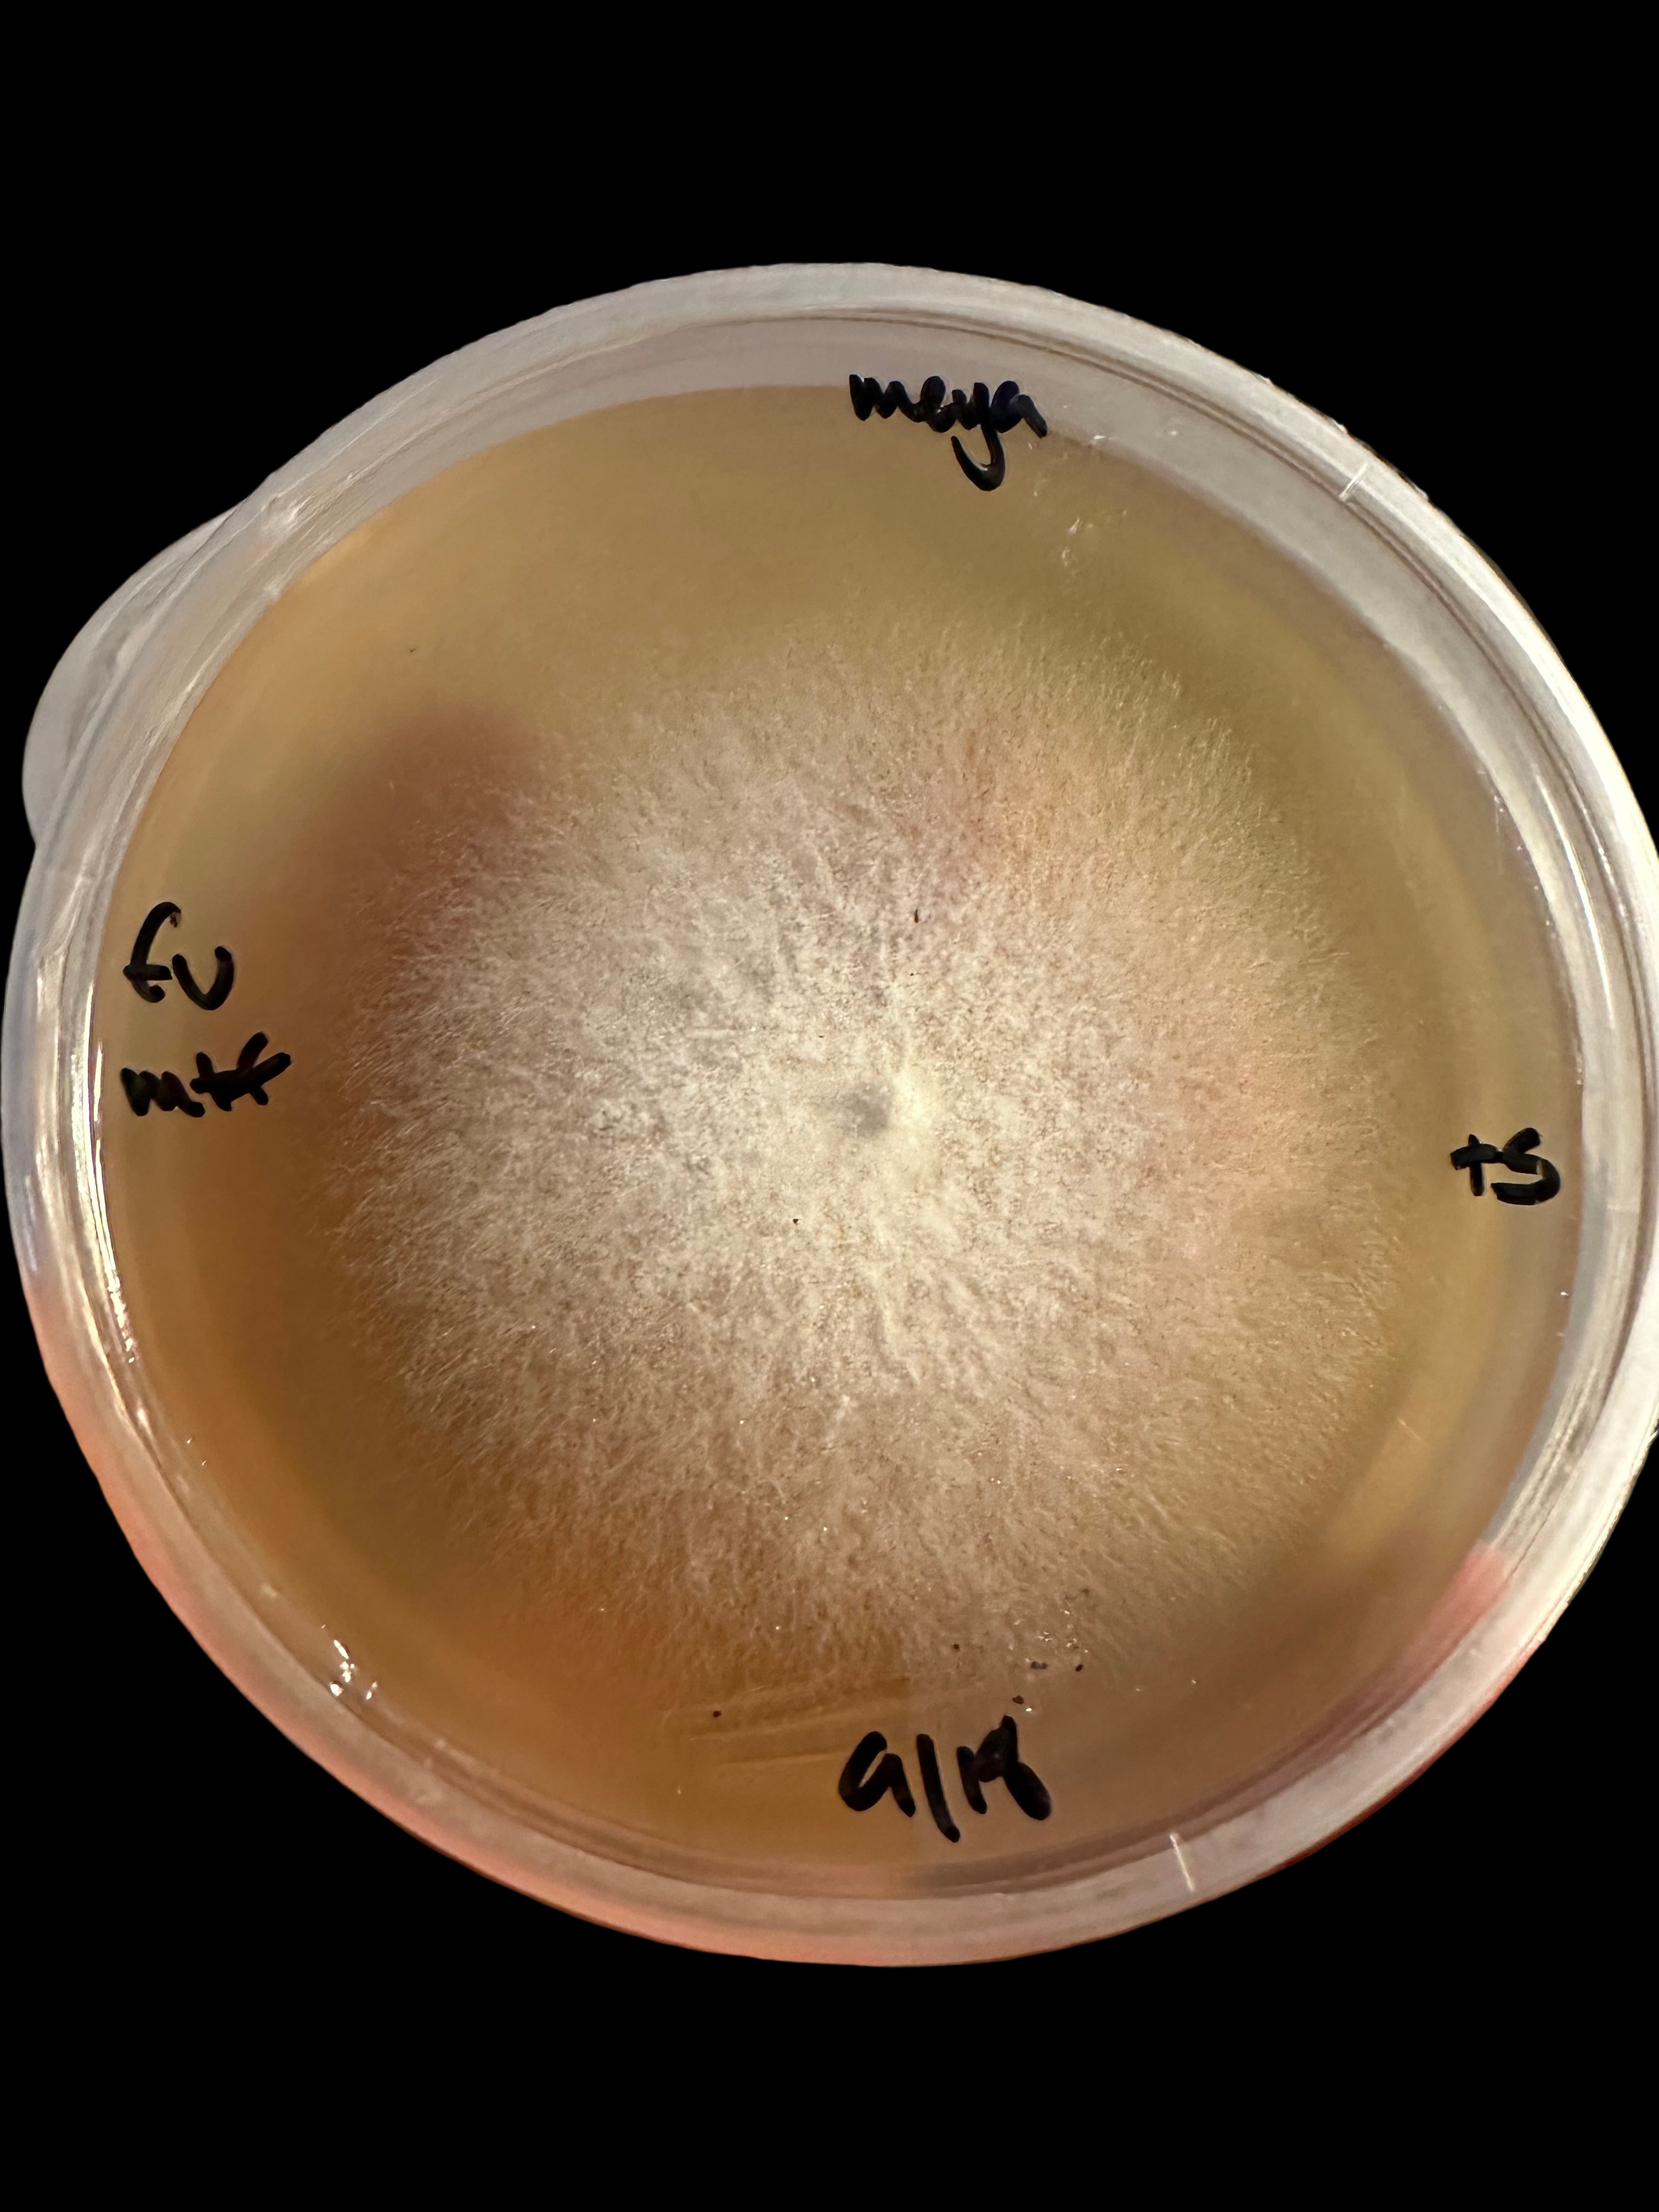

Fungoriam Alchimiam
Welcome to the Fungoriam!
Fungoriam Alchimiam is a carefully curated collection of fungal genetics and specimens, skillfully collected, catalogued and cultured by our experienced mycologist. All cultures in this collection are either collected from the wilds, during my travels or are rare, hard to find or just plain special genetics.
During the past decade of my work with fungi, nothing has been as rewarding as my work with fungal genetics, specifically working with wild cultures. Witnessing their unique journey, from specimen, collected, documented and cataloged to mycelium, flowing under my microscope or travelling across the surface of a solid media gives me great joy and endless hours of attentive co-creation.
This whole journey began as a way of finding deeper intimacy with nature, and this work has done exactly that.
We hope to help you curate an intimacy with nature and ultimately deepening relationship with yourself through this work.
I'm honored to be able to curate The Fungoriam, and offer these truly unique and special specimens to you and yours!